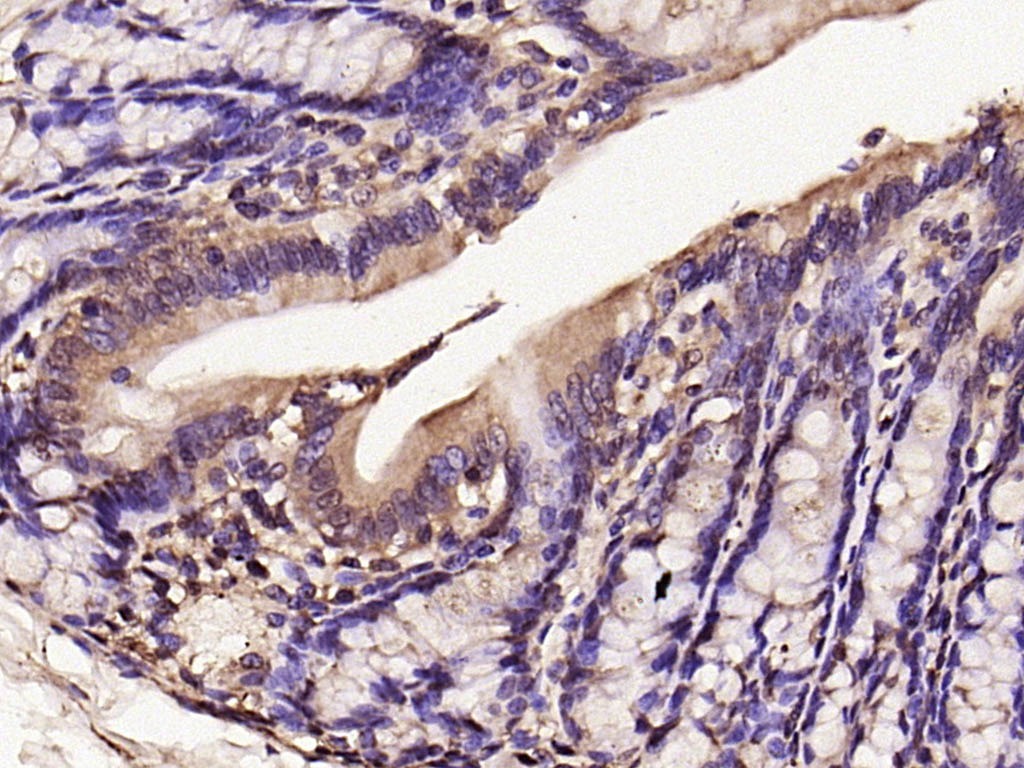
verifiedActivity

您的购物车当前为空
您的购物车当前为空
Anti-iNOS Polyclonal Antibody 3
一键复制产品信息产品编号 TMAB-00972
别名 NOS2A, NOS2, NOS type II, Nos II, NOS 2A, NOS 2, NOS, Nitric Oxide Synthase, Inducible, Nitric oxide synthase inducible, Nitric oxide synthase 2A(inducible hepatocytes), Nitric oxide synthase 2 inducible macrophage, Macrophage NOS, MAC NOS, Inosl, INOS, Inducible NOS, Inducible NO synthase, Inducible nitric oxide synthase, i NOS, HEPNOS, Hepatocyte NOS, HEP NOS
Anti-iNOS Polyclonal Antibody 3 是一种 Rabbit 抗体,靶向 iNOS。Anti-iNOS Polyclonal Antibody 3 可用于 IF,IHC-Fr,IHC-P。
Anti-iNOS Polyclonal Antibody 3
Anti-iNOS Polyclonal Antibody 3
一键复制产品信息产品编号 TMAB-00972 别名 NOS2A, NOS2, NOS type II, Nos II, NOS 2A, NOS 2, NOS, Nitric Oxide Synthase, Inducible, Nitric oxide synthase inducible, Nitric oxide synthase 2A(inducible hepatocytes), Nitric oxide synthase 2 inducible macrophage, Macrophage NOS, MAC NOS, Inosl, INOS, Inducible NOS, Inducible NO synthase, Inducible nitric oxide synthase, i NOS, HEPNOS, Hepatocyte NOS, HEP NOS
Anti-iNOS Polyclonal Antibody 3 是一种 Rabbit 抗体,靶向 iNOS。Anti-iNOS Polyclonal Antibody 3 可用于 IF,IHC-Fr,IHC-P。
| 规格 | 价格 | 库存 | 数量 |
|---|---|---|---|
| 50 μL | ¥ 1,160 | 5日内发货 | |
| 100 μL | ¥ 1,960 | 5日内发货 | |
| 200 μL | ¥ 2,795 | 5日内发货 |
大包装 & 定制
加入购物车
TargetMol 的所有产品仅用作科学研究或药证申报,不能被用于人体,我们不向个人提供产品和服务。请您遵守承诺用途,不得违反法律法规规定用于任何其他用途。
Anti-iNOS Polyclonal Antibody 3 相关产品
资源下载
产品介绍
生物活性
抗原信息
化学信息
| 产品描述 | Anti-iNOS Polyclonal Antibody 3 is a Rabbit antibody targeting iNOS. Anti-iNOS Polyclonal Antibody 3 can be used in IF,IHC-Fr,IHC-P. |
| 别名 | NOS2A, NOS2, NOS type II, Nos II, NOS 2A, NOS 2, NOS, Nitric Oxide Synthase, Inducible, Nitric oxide synthase inducible, Nitric oxide synthase 2A(inducible hepatocytes), Nitric oxide synthase 2 inducible macrophage, Macrophage NOS, MAC NOS, Inosl, INOS, Inducible NOS, Inducible NO synthase, Inducible nitric oxide synthase, i NOS, HEPNOS, Hepatocyte NOS, HEP NOS |
| Ig Type | IgG |
| 交叉反应 | Rat (predicted:Mouse,Rabbit) |
| 验证活性 | Paraformaldehyde-fixed, paraffin embedded (rat colon); Antigen retrieval by boiling in sodium citrate buffer (pH6.0) for 15 min; Block endogenous peroxidase by 3% hydrogen peroxide for 20 min; Blocking buffer (normal goat serum) at 37°C for 30 min; Antibody incubation with (iNos) Polyclonal Antibody, Unconjugated (TMAB-00972) at 1:200 overnight at 4°C, followed by operating according to SP Kit (Rabbit) instructionsand DAB staining. |
| 应用 | IFIHC-FrIHC-P |
| 推荐剂量 | IHC-P: 1:400-800; IHC-Fr: 1:400-800; IF: 1:100-500 |
| 抗体种类 | Polyclonal |
| 宿主来源 | Rabbit |
| 亚细胞定位 | Cytosol |
| 组织特异性 | Expressed in the liver, retina, bone cells and airway epithelial cells of the lung. Not expressed in the platelets. |
| 构建方式 | Polyclonal Antibody |
| 纯化方式 | Protein A purified |
| 性状 | Liquid |
| 缓冲液 | 0.01M TBS (pH7.4) with 1% BSA, 0.02% Proclin300 and 50% Glycerol. |
| 浓度 | 1 mg/mL |
| 研究背景 | Nitric oxide (NO) is an inorganic, gaseous free radical that carries a variety of messages between cells. Vasorelaxation, neurotransmission and cytotoxicity can all be potentiated through cellular response to NO. NO production is mediated by members of the nitric oxide synthase (NOS) family. NOS catalyzes the oxidization of L-arginine to produce L-citrulline and NO. Two constitutive isoforms, brain or neuronal NOS (b or nNOS, type I) & endothelial cell NOS (eNOS, type III), and one inducible isoform (iNOS, type II), have been cloned. All NOS isoforms contain calmodulin, nicotinamide adenine dinucleotide phosphate (NADPH), flavin adenine dinucleotide (FAD), and flavin mononucleotide (FMN) binding domains. Nitric oxide synthase is expressed in liver, macrophages, hepatocytes, synoviocytes, stimulated glial cells and smooth muscle cells. Cytokines such as interferon-gamma (IFN), tumor necrosis factor (TNF), interleukin-1 and -2, and lipopolysaccarides (LPS) cause an increase in iNOS mRNA, protein, and activity levels. Protein kinase C-stimulating agents exhibit the same effect on iNOS activity. After cytokine induction, iNOS exhibits a delayed activity response which is then followed by a significant increase in NO production over a long period of time. Human iNOS is regulated by calcium/calmodulin (in contrast with mouse NOS2). |
| 免疫原 | KLH conjugated synthetic peptide: human iNos/Nos-2 |
| 抗原种属 | Human |
| 基因名称 | NOS2 |
| 基因ID | |
| 蛋白名称 | Nitric oxide synthase, inducible |
| Uniprot ID | |
| 研究领域 | Cellular metabolic process,Response to hypoxia,Hypoxia,NOS |
| 功能 | Produces nitric oxide (NO) which is a messenger molecule with diverse functions throughout the body. In macrophages, NO mediates tumoricidal and bactericidal actions. Also has nitrosylase activity and mediates cysteine S-nitrosylation of cytoplasmic target proteins such COX2. |
| 分子量 | Theoretical: 130 kDa. |
存储&运输
| 储存方式 | Store at -20°C or -80°C for 12 months. Avoid repeated freeze-thaw cycles. |
| 运输方式 | Shipping with blue ice. |
计算器
引用文献
评论列表
Related Tags: buy Anti-iNOS Polyclonal Antibody 3 | purchase Anti-iNOS Polyclonal Antibody 3 | Anti-iNOS Polyclonal Antibody 3 cost | order Anti-iNOS Polyclonal Antibody 3 | Anti-iNOS Polyclonal Antibody 3 molecular weight





 还可以
还可以

 |
|
评论内容